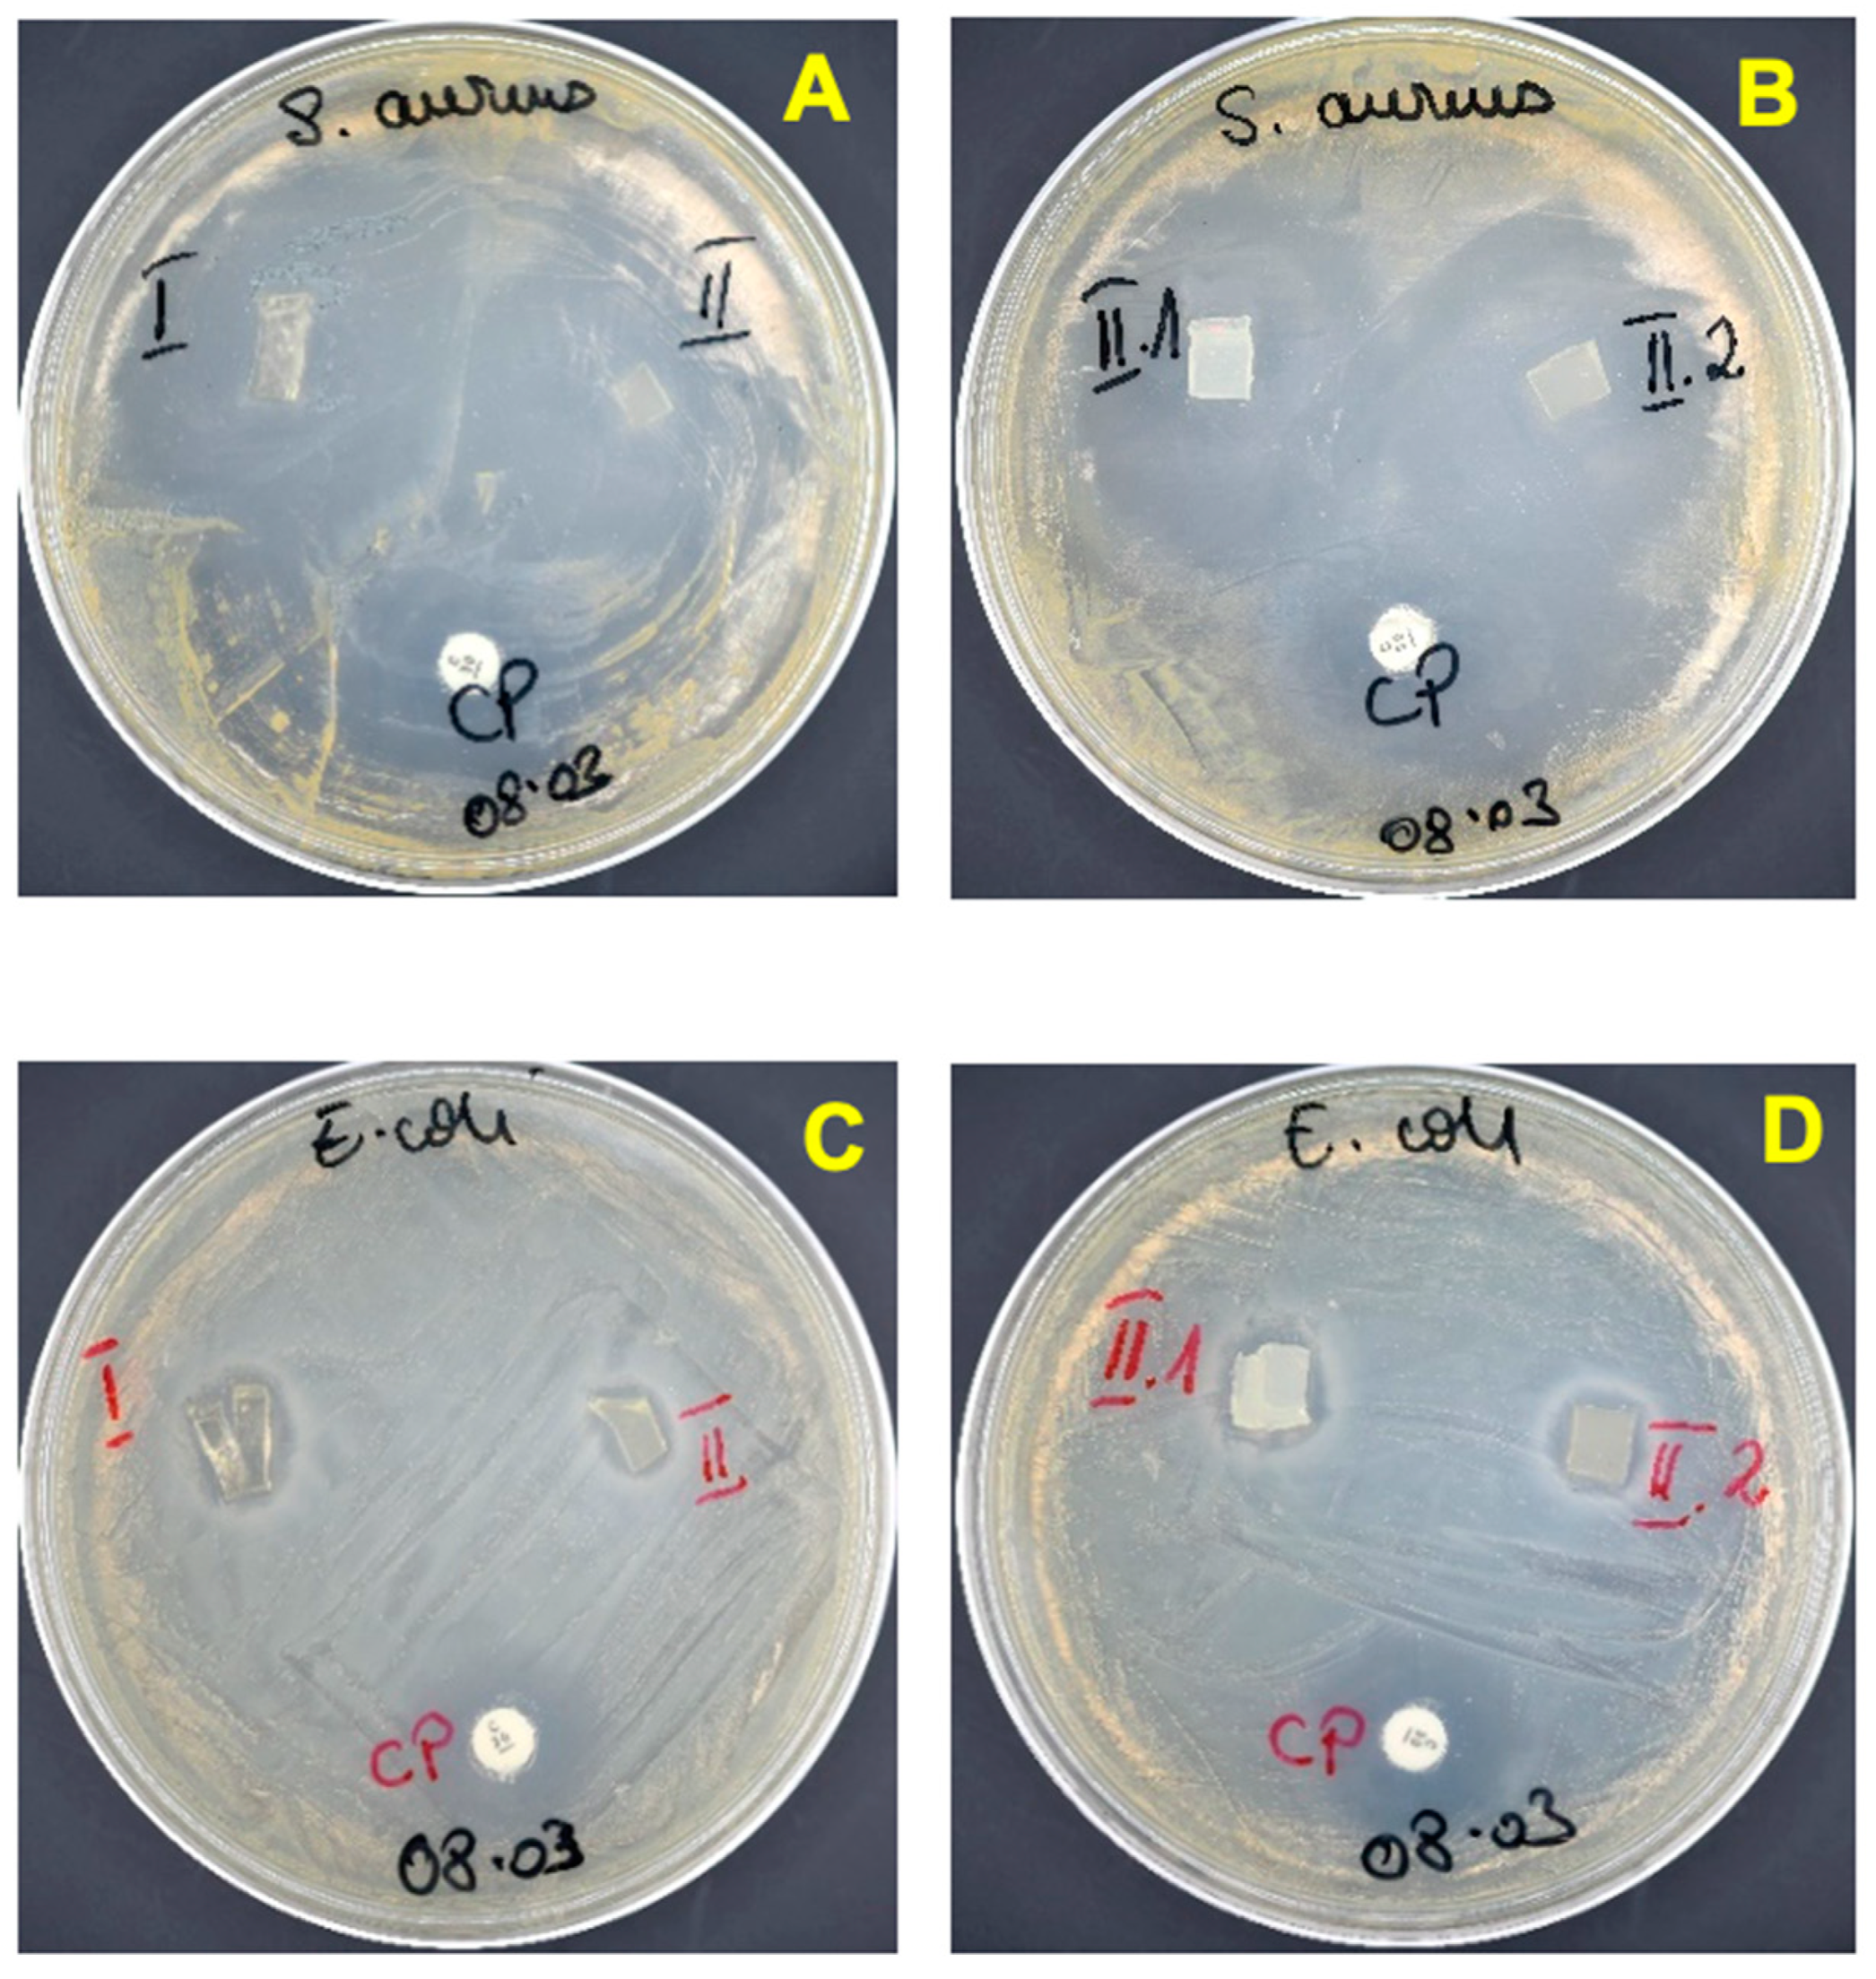
Pharmaceutics 15 01588 g007 Pharmaceutics 15 01588 g007

Nafcillin-Loaded Photocrosslinkable Nanocomposite Hydrogels for Biomedical Applications
Abstract
1. Introduction
2. Materials and Methods
2.1. Materials
2.2. Methods
2.2.1. Synthesis of Photocrosslinkable Nanocomposite Hydrogels
2.2.2. Nafcillin Loading/Release Tests
2.2.3. Evaluation of the Antimicrobial Activity of the Nafcillin-Loaded Nanocomposite Hydrogels
2.3. Characterization
3. Results and Discussions
3.1. Preparation of the Nanocomposite Hydrogels
3.2. Characterization of the Nanocomposite Hydrogels
3.3. Nafcillin Loading and the Evaluation of Drug Release Kinetics
3.4. Evaluation of the Antimicrobial Activity of the Nanocomposite Hydrogels
- (A)
- Agar disc diffusion method
- (B)
- Time-kill assay
4. Conclusions
Supplementary Materials
Author Contributions
Funding
Institutional Review Board Statement
Informed Consent Statement
Data Availability Statement
Acknowledgments
Conflicts of Interest
References
- Farahani, M.; Shafiee, A. Wound Healing: From Passive to Smart Dressings. Adv. Healthc. Mater. 2021, 10, 2100477. [Google Scholar] [CrossRef] [PubMed]
- Liu, L.; Li, X.; Nagao, M.; Elias, A.L.; Narain, R.; Chung, H.-J. A pH-Indicating Colorimetric Tough Hydrogel Patch towards Applications in a Substrate for Smart Wound Dressings. Polymers 2017, 9, 558. Available online: https://www.mdpi.com/2073-4360/9/11/558 (accessed on 10 April 2023). [CrossRef] [PubMed]
- Carvalho, I.C.; Mansur, H.S. Engineered 3D-scaffolds of photocrosslinked chitosan-gelatin hydrogel hybrids for chronic wound dressings and regeneration. Mater. Sci. Eng. C 2017, 78, 690–705. [Google Scholar] [CrossRef] [PubMed]
- Oktar, F.N.; Yetmez, M.; Ficai, D.; Ficai, A.; Dumitru, F.; Pica, A. Molecular mechanism and targets of the antimicrobial activity of metal nanoparticles. Curr. Top. Med. Chem. 2015, 15, 1583–1588. [Google Scholar] [CrossRef]
- Mooney, E.; Lippitt, C.; Friedman, J. Plastic surgery educational foundation data committee: Silver dressings. Plast. Reconstr. Surg. 2006, 117, 666–669. [Google Scholar] [CrossRef]
- Thomson, C.H. Biofilms: Do they affect wound healing? Int. Wound J. 2011, 8, 63–67. [Google Scholar] [CrossRef]
- Thet, N.T.; Alves, D.R.; Bean, J.E.; Booth, S.; Nzakizwanayo, J.; Young, A.E.R.; Jones, B.V.; Jenkins, A.T.A. Prototype Development of the Intelligent Hydrogel Wound Dressing and Its Efficacy in the Detection of Model Pathogenic Wound Biofilms. ACS Appl. Mater. Interfaces 2016, 8, 14909–14919. [Google Scholar] [CrossRef]
- Hao, R.; Cui, Z.; Zhang, X.; Tian, M.; Zhang, L.; Rao, F.; Xue, J. Rational Design and Preparation of Functional Hydrogels for Skin Wound Healing. Front. Chem. 2022, 9, 1275. [Google Scholar] [CrossRef]
- Francesko, A.; Petkova, P.; Tzanov, T. Hydrogel Dressings for Advanced Wound Management. Curr. Med. Chem. 2018, 25, 5782–5797. [Google Scholar] [CrossRef]
- Tamahkar, E.; Özkahraman, B.; Süloğlu, A.K.; Idil, N.; Perçin, I. A novel multilayer hydrogel wound dressing for antibiotic release. J. Drug Deliv. Sci. Technol. 2020, 58, 101536. [Google Scholar] [CrossRef]
- Palmer, D.L.; Pett, S.B.; Akl, B.F. Bacterial wound colonization after broad-spectrum versus narrow-spectrum antibiotics. Ann. Thorac. Surg. 1995, 59, 626–631. [Google Scholar] [CrossRef] [PubMed]
- Teixeira, M.O.; Antunes, J.C.; Felgueiras, H.P. Recent Advances in Fiber–Hydrogel Composites for Wound Healing and Drug Delivery Systems. Antibiotics 2021, 10, 248. [Google Scholar] [CrossRef] [PubMed]
- Ekici, S.; Saraydin, D. Synthesis, Characterization and Evaluation of IPN Hydrogels for Antibiotic Release. Drug Deliv. 2004, 11, 381–388. [Google Scholar] [CrossRef] [PubMed]
- Madaghiele, M.; Demitri, C.; Sannino, A.; Ambrosio, L. Polymeric hydrogels for burn wound care: Advanced skin wound dressings and regenerative templates. Burn. Trauma 2014, 2, 2321–3868. [Google Scholar] [CrossRef] [PubMed]
- Jones, V.; Grey, J.E.; Harding, K.G. Wound dressings. BMJ 2006, 332, 777–780. [Google Scholar] [CrossRef]
- Neblea, I.E.; Gavrila, A.-M.; Iordache, T.; Zaharia, A.; Stanescu, P.O.; Radu, I.-C.; Burlacu, S.G.; Neagu, G.; Chiriac, A.-L.; Sarbu, A. Interpenetrating networks of bacterial cellulose and poly (ethylene glycol) diacrylate as potential cephalexin carriers in wound therapy. J. Polym. Res. 2022, 29, 406. [Google Scholar] [CrossRef]
- Park, K.; Sadeghi, K.; Panda, P.K.; Seo, J.; Seo, J. Ethylene vinyl acetate/low-density polyethylene/oyster shell powder composite films: Preparation, characterization, and antimicrobial properties for biomedical applications. J. Taiwan Inst. Chem. Eng. 2022, 134, 104301. [Google Scholar] [CrossRef]
- Parhi, S.; Pal, S.; Das, S.K.; Ghosh, P. Strategies toward development of antimicrobial biomaterials for dental healthcare applications. Biotechnol. Bioeng. 2021, 118, 4590–4622. [Google Scholar] [CrossRef]
- Panda, P.K.; Sadeghi, K.; Park, K.; Seo, J. Regeneration Approach to Enhance the Antimicrobial and Antioxidant Activities of Chitosan for Biomedical Applications. Polymers 2022, 15, 132. [Google Scholar] [CrossRef]
- Mondal, S.; Das, S.; Nandi, A.K. A review on recent advances in polymer and peptide hydrogels. Soft Matter 2020, 16, 1404–1454. [Google Scholar] [CrossRef]
- Franco, P.; De Marco, I. The Use of Poly(N-vinyl pyrrolidone) in the Delivery of Drugs: A Review. Polymers 2020, 12, 1114. Available online: https://www.mdpi.com/2073-4360/12/5/1114 (accessed on 15 April 2023). [CrossRef] [PubMed]
- Edikresnha, D.; Suciati, T.; Munir, M.M.; Khairurrijal, K. Polyvinylpyrrolidone/cellulose acetate electrospun composite nanofibres loaded by glycerine and garlic extract with in vitro antibacterial activity and release behaviour test. RSC Adv. 2019, 9, 26351–26363. [Google Scholar] [CrossRef] [PubMed]
- Razzak, M.T.; Darwis, D.; Zainuddin, H. Sukirno Irradiation of polyvinyl alcohol and polyvinyl pyrrolidone blended hydrogel for wound dressing. Radiat. Phys. Chem. 2001, 62, 107–113. [Google Scholar] [CrossRef]
- Mateescu, A.; Wang, Y.; Dostalek, J.; Jonas, U. Thin Hydrogel Films for Optical Biosensor Applications. Membranes 2012, 2, 40–69. [Google Scholar] [CrossRef]
- Bae, J.; Park, J.; Kim, S.; Cho, H.; Kim, H.J.; Park, S.; Shin, D.S. Tailored hydrogels for biosensor applications. J. Ind. Eng. Chem. 2020, 89, 1–12. [Google Scholar] [CrossRef]
- Foudazi, R.; Zowada, R.; Manas-Zloczower, I.; Feke, D.L. Porous Hydrogels: Present Challenges and Future Opportunities. Langmuir 2023, 39, 2092–2111. [Google Scholar] [CrossRef]
- Ma, H.; Peng, Y.; Zhang, S.; Zhang, Y.; Min, P. Effects and Progress of Photo-Crosslinking Hydrogels in Wound Healing Improvement. Gels 2022, 8, 609. [Google Scholar] [CrossRef]
- Neumann, M.G.; Schmitt, C.C.; Catalina, F.; Goi, B.E. The relation between the polymerization rates and swelling coefficients for copolymers obtained by photoinitiation. Polym. Test. 2007, 26, 189–194. [Google Scholar] [CrossRef]
- Ozdal, M.; Gurkok, S. A Recent advances in nanoparticles as antibacterial agent. ADMET DMPK 2022, 10, 115–129. [Google Scholar] [CrossRef]
- Zhang, M.; Qiao, X.; Han, W.; Jiang, T.; Liu, F.; Zhao, X. Alginate-chitosan oligosaccharide-ZnO composite hydrogel for accelerating wound healing. Carbohydr. Polym. 2021, 266, 118100. [Google Scholar] [CrossRef]
- Palantöken, A.; Yilmaz, M.S.; Yapaöz, M.A.; Pişkin, S. Investigation of antibacterial properties of hydrogel containing synthesized TiO2 nanoparticles. Sigma J. Eng. Nat. Sci. 2015, 33, 1–7. [Google Scholar]
- Kumar, S.S.D.; Rajendran, N.K.; Houreld, N.N.; Abrahamse, H. Recent advances on silver nanoparticle and biopolymer-based biomaterials for wound healing applications. Int. J. Biol. Macromol. 2018, 115, 165–175. [Google Scholar] [CrossRef] [PubMed]
- Wang, Y.; Wu, Y.; Long, L.; Yang, L.; Fu, D.; Hu, C.; Kong, Q.; Wang, Y. Inflammation-responsive drug-loaded hydrogels with sequential hemostasis, antibacterial, and anti-inflammatory behavior for chronically infected diabetic wound treatment. ACS Appl. Mater. Interfaces 2021, 13, 33584–33599. [Google Scholar] [CrossRef] [PubMed]
- Loo, S.; Vásquez, L.; Athanassiou, A.; Fragouli, D. Polymeric Hydrogels—A Promising Platform in Enhancing Water Security for a Sustainable Future. Adv. Mater. Interfaces 2021, 8, 2100580. [Google Scholar] [CrossRef]
- Mathur, S.; Sutton, J. Personalized medicine could transform healthcare. Biomed. Rep. 2017, 7, 3–5. [Google Scholar] [CrossRef]
- Ramasubbu, D.A.; Smith, V.; Hayden, F.; Cronin, P. Systemic antibiotics for treating malignant wounds. Cochrane Database Syst. Rev. 2017, 1–23. [Google Scholar] [CrossRef]
- Kopač, T.; Ručigaj, A.; Krajnc, M. The mutual effect of the crosslinker and biopolymer concentration on the desired hydrogel properties. Int. J. Biol. Macromol. 2020, 159, 557–569. [Google Scholar] [CrossRef]
- Smith, R.; Russo, J.; Fiegel, J.; Brogden, N. Antibiotic Delivery Strategies to Treat Skin Infections When Innate Antimicrobial Defense Fails. Antibiotics 2020, 9, 56. [Google Scholar] [CrossRef]
- Everts, R. How to Treat Wound Infection. Prev. Treat. 2016. Available online: https://www.acc.co.nz/assets/provider/treating-wound-infections.pdf (accessed on 5 May 2023).
- Altun, E.; Yuca, E.; Ekren, N.; Kalaskar, D.M.; Ficai, D.; Dolete, G.; Ficai, A.; Gunduz, O. Kinetic Release Studies of Antibiotic Patches for Local Transdermal Delivery. Pharmaceutics 2021, 13, 613. [Google Scholar] [CrossRef]
- Katime, I.; Sáez, V.; Hernáez, E. Nafcillin release from poly (Acrylic acid–co–methyl methacrylate) hydrogels. Polym. Bull. 2005, 55, 403–409. [Google Scholar] [CrossRef]
- Si, H.; Xing, T.; Ding, Y.; Zhang, H.; Yin, R. 3D Bioprinting of the Sustained Drug Release Wound Dressing with Double-Crosslinked Hyaluronic-Acid-Based Hydrogels. Polymers 2019, 11, 1584. [Google Scholar] [CrossRef] [PubMed]
- Castle, S.S. Nafcillin. In xPharm: The Comprehensive Pharmacology Reference; Enna, S.J., Bylund, D.B., Eds.; Elsevier: New York, NY, USA, 2007; pp. 1–4. [Google Scholar]
- Vardanian, R.; Hruby, V.J. Synthesis of Essential Drugs; Elsevier: Amsterdam, The Netherlands, 2006. [Google Scholar]
- Le, J.; Dam, Q.; Schweizer, M.; Thienphrapa, W.; Nizet, V.; Sakoulas, G. Effects of vancomycin versus nafcillin in enhancing killing of methicillin-susceptible Staphylococcus aureus causing bacteremia by human cathelicidin LL-37. Eur. J. Clin. Microbiol. Infect. Dis. 2016, 35, 1441–1447. [Google Scholar] [CrossRef] [PubMed]
- Sabbagh, F.; Kim, B.S. Recent advances in polymeric transdermal drug delivery systems. J. Control. Release 2022, 341, 132–146. [Google Scholar] [CrossRef] [PubMed]
- Ginghina, R.-E.; Toader, G.; Purica, M.; Bratu, A.-E.; Lazaroaie, C.; Tiganescu, T.-V.; Oncioiu, R.-E.; Iorga, G.-O.; Zorila, F.-L.; Constantin, M.; et al. Antimicrobial Activity and Degradation Ability Study on Nanoparticle-Enriched Formulations Specially Designed for the Neutralization of Real and Simulated Biological and Chemical Warfare Agents. Pharmaceuticals 2022, 15, 97. Available online: https://www.mdpi.com/1424-8247/15/1/97 (accessed on 20 April 2023). [CrossRef] [PubMed]
- Borges, A.; Abreu, A.C.; Ferreira, C.; Saavedra, M.J.; Simões, L.C.; Simões, M. Antibacterial activity and mode of action of selected glucosinolate hydrolysis products against bacterial pathogens. J. Food Sci. Technol. 2015, 52, 4737–4748. [Google Scholar] [CrossRef]
- Clinical and Laboratory Standards Institute. Methods for Dilution Antimicrobial Susceptibility Tests for Bacteria That Grow Aerobically; Approved Standard—Ninth Edition. CLSI document M07-A9; Clinical and Laboratory Standards Institute: Wayne, PA, USA, 2018; Volume 32, p. 18. [Google Scholar]
- Rang, H.P.; Dale, M.M.; Ritter, J.M.; Flower, R.J.; Henderson, G. Rang Dale’s Pharmacology; Elsevier Health Sciences: London, UK, 2011. [Google Scholar]
- Hartman, D. Perfecting your spread plate technique. J. Microbiol. Biol. Educ. 2011, 12, 204–205. [Google Scholar] [CrossRef]
- Macron, J.; Bresson, B.; Tran, Y.; Hourdet, D.; Creton, C. Equilibrium and Out-of-Equilibrium Adherence of Hydrogels against Polymer Brushes. Macromolecules 2018, 51, 7556–7566. [Google Scholar] [CrossRef]
- Ninciuleanu, C.M.; Ianchiş, R.; Alexandrescu, E.; Mihăescu, C.I.; Scomoroşcenco, C.; Nistor, C.L.; Preda, S.; Petcu, C.; Teodorescu, M. The effects of monomer, crosslinking agent, and filler concentrations on the viscoelastic and swelling properties of poly (methacrylic acid) hydrogels: A comparison. Materials 2021, 14, 2305. [Google Scholar] [CrossRef]
- Toader, G.; Ginghina, R.E.; Diacon, A.; Rusen, E.; Bratu, A.E.; Podaru, A.; Rotariu, T. Design and Application of Photocrosslinkable Hydrogel Films for Fast and Efficient Decontamination of Chemical Warfare Agents. ACS Appl. Polym. Mater. 2023, 5, 877–891. [Google Scholar] [CrossRef]
- Polat, T.G.; Duman, O.; Tunç, S. Preparation and characterization of environmentally friendly agar/κ-carrageenan/montmorillonite nanocomposite hydrogels. Colloids Surfaces A Physicochem. Eng. Asp. 2020, 602, 124987. [Google Scholar] [CrossRef]
- Abbas, S.; Ahmad, B.; Iqbal, Z.; Bashir, S.; Ali, J. Study and evaluation of poly (n-vinyl-2-pyrrolidone) hydrogel swelling, theophylline loading and release. World Appl. Sci. 2013, 27, 236–249. [Google Scholar]
- Maiz-Fernández, S.; Pérez-Álvarez, L.; Silván, U.; Vilas-Vilela, J.L.; Lanceros-Mendez, S. Photocrosslinkable and self-healable hydrogels of chitosan and hyaluronic acid. Int. J. Biol. Macromol. 2022, 216, 291–302. [Google Scholar] [CrossRef] [PubMed]
- Kirillov, E.; Rodygin, K.; Ananikov, V. Recent advances in applications of vinyl ether monomers for precise synthesis of custom-tailored polymers. Eur. Polym. J. 2020, 136, 109872. [Google Scholar] [CrossRef]
- Ravindran, N.; Vora, A.; Webster, D.C. Effect of polymer composition on performance properties of maleate-vinyl ether donor-acceptor UV-curable systems. J. Coatings Technol. Res. 2006, 3, 213–219. [Google Scholar] [CrossRef]
- Heinlaan, M.; Ivask, A.; Blinova, I.; Dubourguier, H.-C.; Kahru, A. Toxicity of nanosized and bulk ZnO, CuO and TiO2 to bacteria Vibrio fischeri and crustaceans Daphnia magna and Thamnocephalus platyurus. Chemosphere 2008, 71, 1308–1316. [Google Scholar] [CrossRef]
- Luksiene, Z. 16-Nanoparticles and Their Potential Application as Antimicrobials in the Food Industry. In Food Preservation; Grumezescu, A.M., Ed.; Academic Press: Cambridge, MA, USA, 2017; pp. 567–601. [Google Scholar]
- Kheirabadi, M.; Bagheri, R.; Kabiri, K. Swelling and mechanical behavior of nanoclay reinforced hydrogel: Single network vs. full interpenetrating polymer network. Polym. Bull. 2015, 72, 1663–1681. [Google Scholar] [CrossRef]
- Sakr, M.A.; Mohamed, M.G.; Wu, R.; Shin, S.R.; Kim, D.; Kim, K.; Siddiqua, S. Development of bentonite-gelatin nanocomposite hybrid hydrogels for tissue engineering. Appl. Clay Sci. 2020, 199, 105860. [Google Scholar] [CrossRef]
- Chueangchayaphan, W.; Luangchuang, P.; Chueangchayaphan, N. High Performance of Titanium Dioxide Reinforced Acrylonitrile Butadiene Rubber Composites. Polymers 2022, 14, 5267. Available online: https://www.mdpi.com/2073-4360/14/23/5267 (accessed on 15 April 2023). [CrossRef]
- Alam, M.N.; Kumar, V.; Park, S.-S. Advances in Rubber Compounds Using ZnO and MgO as Co-Cure Activators. Polymers 2022, 14, 5289. Available online: https://www.mdpi.com/2073-4360/14/23/5289 (accessed on 17 April 2023). [CrossRef]
- Miotke, M.; Strankowska, J.; Kwela, J.; Strankowski, M.; Józefowicz, M. Transport of paracetamol in swellable and relaxing polyurethane nanocomposite hydrogels. Polym. Bull. 2020, 77, 483–499. [Google Scholar] [CrossRef]
- Khan, S.; Ranjha, N.M. Effect of degree of cross-linking on swelling and on drug release of low viscous chitosan/poly(vinyl alcohol) hydrogels. Polym. Bull. 2014, 71, 2133–2158. [Google Scholar] [CrossRef]
- Ionescu, M.; Sinharoy, S.; Petrović, Z.S. Polyacetal polyols for polyurethanes. J. Polym. Environ. 2009, 17, 123–130. [Google Scholar] [CrossRef]
- Meng, Z.; Thakur, T.; Chitrakar, C.; Jaiswal, M.K.; Gaharwar, A.K.; Yakovlev, V.V. Assessment of Local Heterogeneity in Mechanical Properties of Nanostructured Hydrogel Networks. ACS Nano 2017, 11, 7690–7696. [Google Scholar] [CrossRef] [PubMed]
- Guccini, V.; Phiri, J.; Trifol, J.; Rissanen, V.; Mousavi, S.M.; Vapaavuori, J.; Tammelin, T.; Maloney, T.; Kontturi, E. Tuning the Porosity, Water Interaction, and Redispersion of Nanocellulose Hydrogels by Osmotic Dehydration. ACS Appl. Polym. Mater. 2022, 4, 24–28. [Google Scholar] [CrossRef] [PubMed]
- Nicodemus, G.D.; Bryant, S.J. Cell Encapsulation in Biodegradable Hydrogels for Tissue Engineering Applications. Tissue Eng. Part B Rev. 2008, 14, 149–165. [Google Scholar] [CrossRef]
- Basu, A.; Lindh, J.; Ålander, E.; Strømme, M.; Ferraz, N. On the use of ion-crosslinked nanocellulose hydrogels for wound healing solutions: Physicochemical properties and application-oriented biocompatibility studies. Carbohydr. Polym. 2017, 174, 299–308. [Google Scholar] [CrossRef] [PubMed]
- Stojkov, G.; Niyazov, Z.; Picchioni, F.; Bose, R.K. Relationship between Structure and Rheology of Hydrogels for Various Applications. Gels 2021, 7, 255. Available online: https://www.mdpi.com/2310-2861/7/4/25 (accessed on 15 April 2023). [CrossRef] [PubMed]
- Jamburidze, A.; De Corato, M.; Huerre, A.; Pommella, A.; Garbin, V. High-frequency linear rheology of hydrogels probed by ultrasound-driven microbubble dynamics. Soft Matter 2017, 13, 3946–3953. [Google Scholar] [CrossRef]
- Ravindran, N.; Vora, A.; Webster, D.C. Properties of nanocomposites based on maleate-vinyl ether donor—acceptor UV-curable systems. J. Appl. Polym. Sci. 2007, 105, 3378–3390. [Google Scholar] [CrossRef]
- Pillai, R.R.; Somayaji, S.N.; Rabinovich, M.; Hudson, M.C.; E Gonsalves, K. Nafcillin-loaded PLGA nanoparticles for treatment of osteomyelitis. Biomed. Mater. 2008, 3, 034114. [Google Scholar] [CrossRef]
- Shah, S.R.; Henslee, A.M.; Spicer, P.P.; Yokota, S.; Petrichenko, S.; Allahabadi, S.; Bennett, G.N.; Wong, M.E.; Kasper, F.; Mikos, A.G. Effects of Antibiotic Physicochemical Properties on Their Release Kinetics from Biodegradable Polymer Microparticles. Pharm. Res. 2014, 31, 3379–3389. [Google Scholar] [CrossRef] [PubMed]
- Wise, D.L. Handbook of Pharmaceutical Controlled Release Technology; CRC Press: Boca Raton, FL, USA, 2000. [Google Scholar]
- Olejnik, A.; Kapuscinska, A.; Schroeder, G.; Nowak, I. Physico-chemical characterization of formulations containing endomorphin-2 derivatives. Amino Acids 2017, 49, 1719–1731. [Google Scholar] [CrossRef] [PubMed]
- Malekjani, N.; Jafari, S.M. Modeling the release of food bioactive ingredients from carriers/nanocarriers by the empirical, semiempirical, and mechanistic models. Compr. Rev. Food Sci. Food Saf. 2021, 20, 3–47. [Google Scholar] [CrossRef]
- Heredia, N.S.; Vizuete, K.; Flores-Calero, M.; Pazmiño, V.K.; Pilaquinga, F.; Kumar, B.; Debut, A. Comparative statistical analysis of the release kinetics models for nanoprecipitated drug delivery systems based on poly(lactic-co-glycolic acid). PLoS ONE 2022, 17, e0264825. [Google Scholar] [CrossRef] [PubMed]
- Uskoković, V. Mechanism of formation governs the mechanism of release of antibiotics from calcium phosphate nanopowders and cements in a drug-dependent manner. J. Mater. Chem. B 2019, 7, 3982–3992. [Google Scholar] [CrossRef]
- Livingston, D.H.; Shumate, C.R.; Polk, H.C.; Malangoni, M.A. More is Better. Antibiotic management after hemorrhagic shock. Ann. Surg. 1988, 208, 451–459. [Google Scholar] [CrossRef]
- Barry, A.L.; Garcia, F.; Thrupp, L.D. An Improved Single-disk Method for Testing the Antibiotic Susceptibility of Rapidly-growing Pathogens. Am. J. Clin. Pathol. 1970, 53, 149–158. [Google Scholar] [CrossRef]
- Bauer, A. Antibiotic susceptibility testing by a standardized single diffusion method. Am. J. Clin. Pathol. 1966, 45, 493–496. [Google Scholar] [CrossRef]
- Wilkins, T.D.; Holdeman, L.V.; Abramson, I.J.; Moore, W.E.C. Standardized Single-Disc Method for Antibiotic Susceptibility Testing of Anaerobic Bacteria. Antimicrob. Agents Chemother. 1972, 1, 451–459. [Google Scholar] [CrossRef]
- Hudzicki, J. Kirby-Bauer disk diffusion susceptibility test protocol. Am. Soc. Microbiol. 2009, 15, 55–63. [Google Scholar]
- Campos, S.; Salazar, R.; Arancibia-Miranda, N.; Rubio, M.A.; Aranda, M.; García, A.; Sepúlveda, P.; Espinoza, L.C. Nafcillin degradation by heterogeneous electro-Fenton process using Fe, Cu and Fe/Cu nanoparticles. Chemosphere 2020, 247, 125813. [Google Scholar] [CrossRef] [PubMed]
- Avdic, E. Nafcillin. In Kucers’ The Use of Antibiotics; CRC Press: Boca Raton, FL, USA, 2017; pp. 162–172. [Google Scholar]
- Quintiliani, R. Pharmacodynamics of antimicrobial agents: Time-dependent vs. concentration-dependent killing. Eur. J. Clin. Microbiol. Infect Desease 2001, 1–4. Available online: http://antimicrobe.org/h04c.files/history/PK-PD%20Quint.pdf (accessed on 1 January 2023).
- Craig, W. Pharmacodynamics of antimicrobial agents as a Basis for Determining Dosage Regimens. Eur. J. Clin. Microbiol. Infect. Dis. 1993, 12, S6–S8. [Google Scholar] [CrossRef] [PubMed]

| Sample Code | BT, wt % * | TiO2, wt % * | ZnO, wt % * | NVP, g | TEGDVE, g | Ph-In, g | Water, mL |
|---|---|---|---|---|---|---|---|
| P1 | - | - | - | 1.2 | 0.09 | 0.006 | 4.5 |
| P1-TiO2 | - | 0.1 | - | 1.2 | 0.09 | 0.006 | 4.5 |
| P1-ZnO | - | - | 0.1 | 1.2 | 0.09 | 0.006 | 4.5 |
| P2 | 0.2 | - | - | 1.2 | 0.09 | 0.006 | 4.5 |
| P2-TiO2 | 0.2 | 0.1 | - | 1.2 | 0.09 | 0.006 | 4.5 |
| P2-ZnO | 0.2 | - | 0.1 | 1.2 | 0.09 | 0.006 | 4.5 |
| 1.2 | 0.09 | 0.006 | 4.5 | ||||
| Mathematical Model | P1 | P2 | P2-TiO2 | P2-ZnO |
|---|---|---|---|---|
| Zero order | ||||
| K0, min−1 | 0.49 | 0.36 | 0.23 | 0.41 |
| R2 | 0.87 | 0.90 | 0.79 | 0.89 |
| First order | ||||
| K1, min−1 | 0.0098 | 0.0087 | 0.0033 | 0.01 |
| R2 | 0.66 | 0.66 | 0.70 | 0.62 |
| Higuchi | ||||
| KH, min−0.5 | 8.14 | 5.51 | 4.47 | 7.71 |
| R2 | 0.973 | 0.94 | 0.92 | 0.980 |
| Korsmeyer–Peppas | ||||
| n | 0.69 | 0.735 | 0.627 | 0.960 |
| R2 | 0.985 | 0.983 | 0.979 | 0.988 |
| Nafcillin-Loaded Samples Tested | Sample Code in Microbiological Assays |
|---|---|
| P1 | I. |
| P2 | II. |
| P2-TiO2 | II.1 |
| P2-ZnO | II.2 |
| Positive control | CP |
| Blank reference strains | Bk |
| Samples | No. of CFUs after 1 h | No. of CFUs after 24 h | No. of CFUs after 1 h | No. of CFUs after 24 h |
|---|---|---|---|---|
| S. aureus | E. coli | |||
| I. | 16 × 104 | 106 | 32 × 106 | 98 × 106 |
| II. | 49 × 105 | 14 × 106 | 38 × 106 | 70 × 106 |
| II.1 | 26 × 104 | 19 × 105 | 25 × 106 | 62 × 106 |
| II.2 | 56 × 105 | 45 × 106 | 40 × 106 | 90 × 106 |
| Bk | 22 × 107 | 42 × 107 | 28 × 106 | 46 × 106 |
Disclaimer/Publisher’s Note: The statements, opinions and data contained in all publications are solely those of the individual author(s) and contributor(s) and not of MDPI and/or the editor(s). MDPI and/or the editor(s) disclaim responsibility for any injury to people or property resulting from any ideas, methods, instructions or products referred to in the content. |
© 2023 by the authors. Licensee MDPI, Basel, Switzerland. This article is an open access article distributed under the terms and conditions of the Creative Commons Attribution (CC BY) license (https://creativecommons.org/licenses/by/4.0/).
Share and Cite
Toader, G.; Podaru, I.A.; Rusen, E.; Diacon, A.; Ginghina, R.E.; Alexandru, M.; Zorila, F.L.; Gavrila, A.M.; Trica, B.; Rotariu, T.; et al. Nafcillin-Loaded Photocrosslinkable Nanocomposite Hydrogels for Biomedical Applications. Pharmaceutics 2023, 15, 1588. https://doi.org/10.3390/pharmaceutics15061588
Toader G, Podaru IA, Rusen E, Diacon A, Ginghina RE, Alexandru M, Zorila FL, Gavrila AM, Trica B, Rotariu T, et al. Nafcillin-Loaded Photocrosslinkable Nanocomposite Hydrogels for Biomedical Applications. Pharmaceutics. 2023; 15(6):1588. https://doi.org/10.3390/pharmaceutics15061588
Chicago/Turabian StyleToader, Gabriela, Ionela Alice Podaru, Edina Rusen, Aurel Diacon, Raluca Elena Ginghina, Mioara Alexandru, Florina Lucica Zorila, Ana Mihaela Gavrila, Bogdan Trica, Traian Rotariu, and et al. 2023. "Nafcillin-Loaded Photocrosslinkable Nanocomposite Hydrogels for Biomedical Applications" Pharmaceutics 15, no. 6: 1588. https://doi.org/10.3390/pharmaceutics15061588
APA StyleToader, G., Podaru, I. A., Rusen, E., Diacon, A., Ginghina, R. E., Alexandru, M., Zorila, F. L., Gavrila, A. M., Trica, B., Rotariu, T., & Ionita, M. (2023). Nafcillin-Loaded Photocrosslinkable Nanocomposite Hydrogels for Biomedical Applications. Pharmaceutics, 15(6), 1588. https://doi.org/10.3390/pharmaceutics15061588

